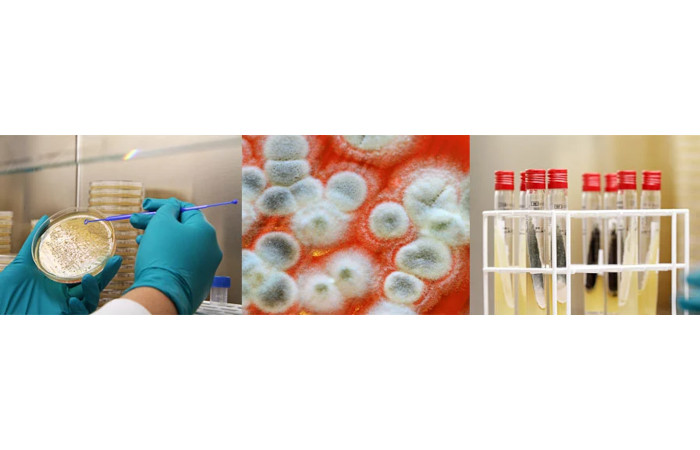
Bio Preserv
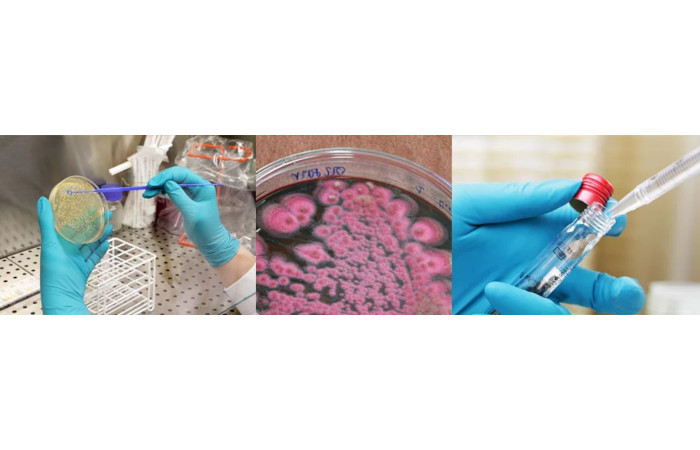
Preserv

BioPreserv

Import: 45
Export: 55
Operation Level: International

06150 Grasse France
Phone: +33 6 74 41 69 00
Web: http://www.biopreserv.fr



|
Maîtrisez la qualité de vos produits et améliorez vos procédés de production. Nos domaines de compétences sont les cosmétiques, les détergents, les matériaux architecturaux et les produits vétérinaires. Nous intervenons également pour tout autre secteur d'activité selon vos problématiques spécifiques.
|
Microbiologie Industrielle




